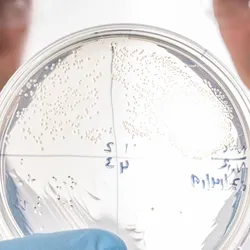
A round, clear petri dish with a clear, speckled film inside is in the foreground. Two men in safety glasses and lab coats are out of focus in the background.

All by University of Michigan
Filter by
AllArticlesAudioEbooksEventsInfographicsNewsProductsSurveysDocumentsVideosVirtual EventsWebinars
New easily interpretable technique can reduce costs and increase scale of protein optimization for multiple applications
| 2 min read

Photonic fibers borrowed from butterfly wings to enable invisible, indelible sorting labels
| 3 min read




















